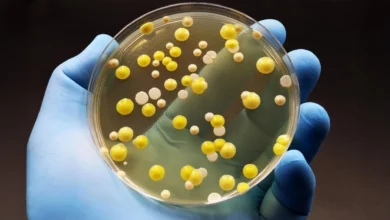

Graphene
-
Health

Graphene kills harmful bacteria “superbugs” but spares human cells
Hygiene is essential for everyday items that come into close contact with the body, including clothing, masks, and toothbrushes. Scientists…
READ FULL STORY
Hygiene is essential for everyday items that come into close contact with the body, including clothing, masks, and toothbrushes. Scientists…
READ FULL STORYOur content is free because of ads. Please support New Trend by disabling your ad blocker.